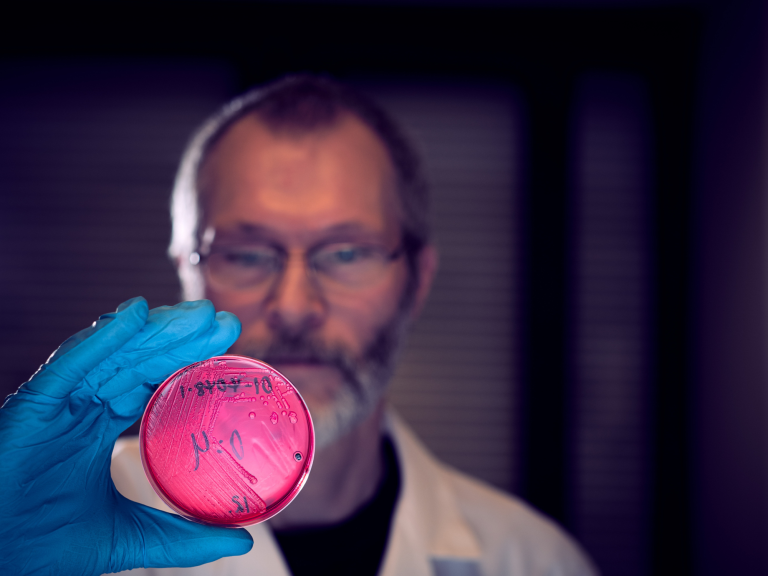

Én helse og antimikrobiell resistens
Antibiotikaresistens (AMR) hos bakterier er et alvorlig og økende problem verden over, og er en trussel for menneskers, dyrs og miljøets helse. Forekomst og spredning av antibiotikaresistens er et resultat av mange års bruk og misbruk av antibiotika til både mennesker, dyr og planter. Når antibiotika brukes tilegner bakterier seg resistens, og allerede resistente bakterier får mulighet til å spre seg. For at vi også i framtiden skal kunne ha effektive antibiotika til behandling av infeksjoner, er det viktig med riktig bruk av antibiotika og kun når det er medisinsk behov for det. AMR er slik en global utfordring som best løses gjennom tverrfaglig og tverrsektorielt samarbeid for Én Helse.
Antibiotikaresistens kan spres mellom forskjellige bakterier, forskjellige dyrearter, samt mellom dyr og mennesker og miljø. Spredning kan skje indirekte via mat og fôr, ved direkte kontakt, eller via handel med dyr, dyreprodukter, mat og fôr, og også gjennom menneskers (og dyrs) reiseaktivitet.
Antibiotikaresistens må slik sees og håndteres i et «Én helse» perspektiv, noe som også er skissert i internasjonale/globale og nasjonale strategier og handlingsplaner mot antibiotikaresistens.
Situasjonen i Norge er god med lite antibiotikaresistens sammenliknet med de fleste andre land. Situasjonen påvirkes av hvor mye antibiotika som benyttes til dyr og mennesker her til lands, men også av faktorer utenfor Norges grenser, samt faktorer som påvirker smittespredning slik som helse, hygiene, biosikkerhet, populasjonstetthet, reiseaktivitet, kjøp og salg av dyr etc. etc.
Status for Norge rapporteres i de årlige NORM/NORM-VET rapportene og har med data på forbruk av antibiotika og forekomst av antibiotikaresistens hos både dyr og mennesker. NORM er overvåkingssystemet innen helsesektoren, mens NORM-VET er AMR overvåkningen i veterinær sektor. NORM-VET har et én helse-fokus da det undersøker for AMR hos dyr og i mat som kan ha betydning for menneskers helse. En rapport utgitt av Veterinærinstituttet i 2021 oppsummerer status for antibiotikaresistens hos dyr og i mat per 2020, med særlig fokus på resistens regnet som viktig i et Én helse – perspektiv.